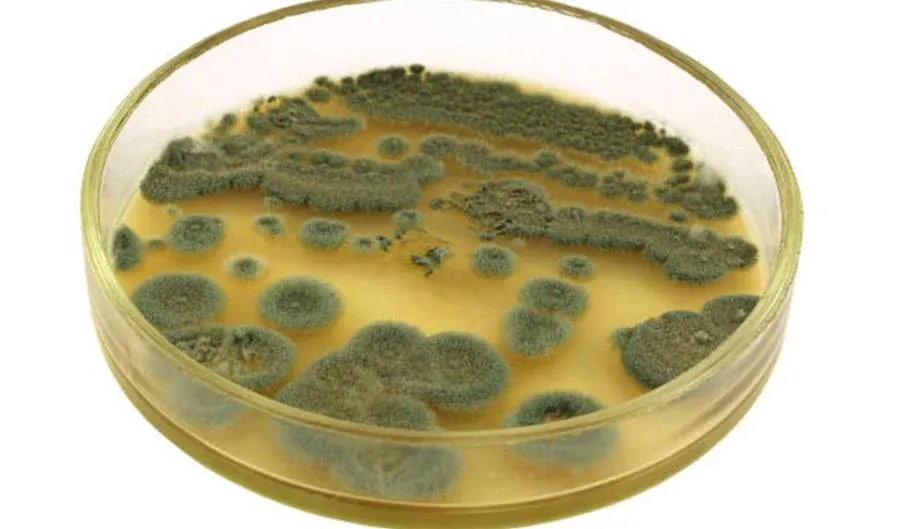
Penicillium bajo microscopio

· Felipe Vengoechea · biologia-fungi
Hongos Imperfectos Explicados: Una Guía Completa sobre Deuteromicetos
Deuteromicetos: Los "hongos imperfectos". Descubre cómo estos organismos sin fase sexual conocida nos dieron la penicilina y transformaron la medicina.

Los Deuteromicetos, conocidos también como hongos imperfectos, representan un grupo de hongos que no encajan fácilmente en la clasificación tradicional. Su nombre proviene del griego “deuteros”, que significa segundo, y “mykes”, que significa hongo, refiriéndose a su naturaleza enigmética.
La categoría de Deuteromicetos fue creada para agrupar aquellos hongos cuyo ciclo de vida carece de una fase sexual conocida o cuya fase sexual no ha sido observada. Esto ha llevado a una clasificación compleja y a menudo controvertida.
[!TIP] Estos “hongos imperfectos” hacen parte de nuestra Guía del Reino Fungi. Explora la clasificación taxonómica completa y entiende cómo los Deuteromicetos se relacionan con Ascomicetos y Basidiomicetos.

Importancia en la biología
Los Deuteromicetos desempeñan un papel vital en diversos ecosistemas. Contribuyen a la descomposición de la materia orgánica, facilitando así el reciclaje de nutrientes en la naturaleza.
Además, algunos Deuteromicetos tienen aplicaciones industriales y médicas, como la producción de antibióticos y enzimas. Su estudio es esencial para comprender la diversidad fúngica y su impacto en la vida humana y en el medio ambiente.
Clasificación General
La clasificación de los Deuteromicetos ha sido un desafío debido a la falta de una fase sexual observable. Tradicionalmente, se clasifican según sus características morfológicas y fisiológicas.
- Forma y Estructura: Se observan las esporas, hifas y otros elementos estructurales.
- Método de Reproducción: Se clasifican según su modo de reproducción asexual.
- Hábitat y ecología: Se considera su ubicación y función en el ecosistema.
A continuación, se presenta una tabla que resume la clasificación general de los Deuteromicetos:
| Característica | Descripción |
|---|---|
| Forma y Estructura | Esporas, hifas, y estructuras complejas |
| Método de Reproducción | Principalmente asexual mediante conidios |
| Hábitat y ecología | Descomponedores, patógenos, simbióticos |
Morfología y Estructura
Los Deuteromicetos presentan una gran diversidad en su morfología y estructura. A continuación, se describen sus principales características:
- Esporas: Las esporas asexuales, conocidas como conidios, son una característica distintiva. Estas pueden variar en forma, tamaño y color.
- Hifas: Las hifas son filamentos que constituyen la estructura principal del hongo. Pueden ser septadas o no septadas, dependiendo de la presencia de divisiones internas.
- Micelio: El micelio es la masa de hifas entrelazadas que forma la estructura visible del hongo. Puede ser superficial o penetrar el sustrato en el que crece el hongo.
- Estructuras Reproductivas: Aunque la reproducción sexual no se observa, existen estructuras especializadas para la reproducción asexual, como los conidióforos.
Nutrición y Modo de Vida
Los Deuteromicetos tienen una nutrición heterotrófica, lo que significa que obtienen su alimento de fuentes orgánicas externas. Sus modos de vida son variados:
- Saprótrofos: Descomponen la materia orgánica muerta, contribuyendo al ciclo de nutrientes.
- Parásitos: Algunos pueden ser patógenos de plantas, animales o incluso otros hongos.
- Simbióticos: Forman relaciones mutualistas con otros organismos, como las micorrizas con las plantas.
Reproducción y Ciclo de Vida
La reproducción en los Deuteromicetos es principalmente asexual. A continuación, se describen las etapas clave:
- Formación de Conidios: Los conidios se forman en estructuras especializadas y se liberan en el ambiente.
- Germinación: Los conidios germinan en condiciones favorables, formando nuevas hifas.
- Crecimiento y Desarrollo: El micelio crece y se desarrolla, pudiendo formar nuevas estructuras reproductivas.
- Dispersión: Los nuevos conidios se liberan y el ciclo continúa.
Ejemplos y Aplicaciones
Los Deuteromicetos incluyen algunos de los hongos más conocidos y útiles. Algunos ejemplos notables son:
- Penicillium: Utilizado en la producción de penicilina, un antibiótico vital.
- Aspergillus: Importante en la industria alimentaria y en la producción de enzimas.
- Candida: Un género que incluye especies patógenas en humanos.
Los Hongos Deuteromicetos: Un Viaje Visual
Dibujos y fotografías
La representación visual de los Deuteromicetos es esencial para comprender su diversidad y complejidad. Los dibujos y fotografías ofrecen una perspectiva única:
- Dibujos Microscópicos: Ilustran las estructuras internas, como las hifas y los conidios, permitiendo una observación detallada.
- Fotografías de Campo: Capturan los Deuteromicetos en su hábitat natural, mostrando su apariencia y contexto ecológico.
Estas imágenes no solo son herramientas educativas sino también una fuente de inspiración artística y científica.
Hongos Deuteromicetos en la Naturaleza
Los Deuteromicetos se encuentran en una amplia variedad de entornos, desde bosques hasta desiertos. Su presencia en la naturaleza es vital para muchos ecosistemas:
- Descomposición: Actúan como descomponedores, descomponiendo la materia orgánica y liberando nutrientes.
- Interacciones ecológicas: Participan en interacciones complejas con otros organismos, como la simbiosis con las plantas.
- Indicadores Ambientales: Su presencia o ausencia puede indicar la salud de un ecosistema.
Enfermedades Causadas por Deuteromicetos
Algunos Deuteromicetos son patógenos y pueden causar enfermedades en plantas, animales y humanos. Algunas enfermedades notables incluyen:
- Candidiasis: Causada por el género Candida, afecta principalmente las membranas mucosas en humanos.
- Aspergilosis: Una infección pulmonar causada por el género Aspergillus.
- Enfermedades de Plantas: Muchos Deuteromicetos son patógenos de plantas, causando enfermedades como la roya y el mildiu.

A continuación, se presenta una tabla que resume algunas enfermedades causadas por Deuteromicetos:
| Enfermedad | Organismo Causante | Afecta a |
|---|---|---|
| Candidiasis | Candida | Humanos |
| Aspergilosis | Aspergillus | Humanos, Animales |
| Roya | Varios géneros | Plantas |
Importancia económica y Beneficios de los Deuteromicetos
Usos Industriales y Médicos
Los Deuteromicetos tienen una amplia gama de aplicaciones industriales y médicas que han revolucionado diversos campos:
- Producción de Antibióticos: El género Penicillium es famoso por la producción de penicilina, el primer antibiótico descubierto.
- Fabricación de Enzimas: Algunos Deuteromicetos producen enzimas utilizadas en la industria alimentaria y en la fabricación de detergentes.
- Biotecnología: Se utilizan en la investigación y desarrollo de nuevos productos y procesos biotecnológicos.
Impacto en la Agricultura
Los Deuteromicetos también juegan un papel crucial en la agricultura:
- Control biológico: Algunas especies se utilizan como agentes de control biológico contra plagas y enfermedades de las plantas.
- Mejora del Suelo: Contribuyen a la descomposición de la materia orgánica, mejorando la calidad y fertilidad del suelo.
- Simbiosis con Plantas: Forman relaciones simbióticas con las plantas, ayudando en la absorción de nutrientes.
Contribución a la Biodiversidad
Los Deuteromicetos son componentes esenciales de la biodiversidad:
- Diversidad ecológica: Ocupan una variedad de nichos ecológicos, desde descomponedores hasta simbiontes.
- Interacciones Complejas: Participan en intrincadas redes alimentarias y relaciones ecológicas.
- Conservación: Su estudio y conservación son vitales para mantener la salud y equilibrio de los ecosistemas.
Desafíos y Consideraciones Éticas
A pesar de sus beneficios, los Deuteromicetos también plantean desafíos y consideraciones éticas:
- Resistencia a Antibióticos: El uso excesivo de antibióticos producidos por Deuteromicetos puede llevar a la resistencia.
- Impacto Ambiental: La gestión inadecuada de los Deuteromicetos en la agricultura puede tener efectos negativos en el medio ambiente.
- Consideraciones Éticas: La biotecnología y la manipulación genética de estos organismos requieren una consideración ética cuidadosa.
Deuteromicetos en la Cultura y la Historia
Mitos y Leyendas
Los Deuteromicetos, como otros hongos, han sido objeto de mitos y leyendas en diversas culturas. Sus formas misteriosas y hábitos de crecimiento han inspirado historias fascinantes:
- Símbolos de Magia: En algunas tradiciones, se cree que los hongos tienen poderes mágicos y se asocian con hechizos y rituales.
- Presagios y Supersticiones: En ciertas culturas, los hongos, incluidos los Deuteromicetos, se consideran presagios de eventos futuros, tanto buenos como malos.
Deuteromicetos en la Literatura y el Arte
Los Deuteromicetos también han encontrado su camino en la literatura y el arte:
- Inspiración Literaria: Han sido la inspiración para poetas y escritores, simbolizando temas como la vida, la muerte y la naturaleza.
- Representación Artística: Los artistas han capturado la belleza y complejidad de los Deuteromicetos en pinturas, esculturas y otras formas de arte.
Impacto en la Ciencia y la Medicina
La influencia de los Deuteromicetos en la ciencia y la medicina es profunda:
- Descubrimiento de la Penicilina: La penicilina, descubierta a partir del género Penicillium, marcó el inicio de la era de los antibióticos.
- Investigación y Desarrollo: Los Deuteromicetos son herramientas valiosas en la investigación científica, contribuyendo al desarrollo de nuevas tecnologías y tratamientos.
Educación y Conciencia Ambiental
La educación sobre los Deuteromicetos es vital para la conciencia ambiental:
- Educación ecológica: La enseñanza sobre los Deuteromicetos fomenta la comprensión de los ecosistemas y la biodiversidad.
- Conservación: La conciencia sobre estos hongos puede llevar a esfuerzos de conservación y protección del medio ambiente.
Los Deuteromicetos han dejado una huella indeleble en la cultura, la historia, la ciencia y la educación. Desde inspirar mitos y arte hasta impulsar avances científicos y médicos, su influencia es vasta y variada. La apreciación y comprensión de estos hongos enriquecen nuestra conexión con el mundo natural y nuestra herencia cultural. Su estudio y celebración fomentan una mayor conciencia y respeto por la diversidad de la vida en nuestro planeta.
Clasificación Detallada y Taxonomía
Clasificación según la Nutrición
La clasificación de los Deuteromicetos puede basarse en su modo de nutrición, lo que refleja su función ecológica:
- Saprótrofos: Obtienen nutrientes de la materia orgánica muerta, desempeñando un papel clave en la descomposición.
- Parásitos: Se alimentan de organismos vivos, pudiendo causar enfermedades.
- Simbióticos: Forman relaciones beneficiosas con otros organismos, como las plantas.
Familias y Géneros
Los Deuteromicetos se dividen en varias familias y géneros, cada uno con características únicas:
- Familia Moniliaceae: Incluye géneros como Aspergillus y Penicillium, conocidos por su importancia médica e industrial.
- Familia Dematiaceae: Contiene hongos oscuros que a menudo son patógenos de plantas.
- Familia Candidaceae: Incluye el género Candida, famoso por causar infecciones en humanos.
Relación con Ascomicetos y Basidiomicetos
La clasificación de los Deuteromicetos ha sido un desafío, y su relación con otros grupos de hongos es compleja:
- Relación con Ascomicetos: Algunos Deuteromicetos han sido reclasificados como Ascomicetos cuando se descubre su fase sexual.
- Relación con Basidiomicetos: Aunque menos común, también hay conexiones con los Basidiomicetos.
A continuación, se presenta una tabla que resume la clasificación detallada de los Deuteromicetos:
| Criterio de Clasificación | Ejemplos |
|---|---|
| Nutrición | Saprótrofos, Parásitos, Simbióticos |
| Familias | Moniliaceae, Dematiaceae, Candidaceae |
| Relación con Otros Hongos | Ascomicetos, Basidiomicetos |
La clasificación detallada y la taxonomía de los Deuteromicetos son fundamentales para comprender su diversidad y relaciones. La clasificación según la nutrición, las familias y géneros, y su relación con otros grupos de hongos, ofrece una visión completa de su posición en el reino de los hongos. La tabla proporciona una representación visual clara y concisa de estos aspectos clave. La comprensión de la clasificación y taxonomía de los Deuteromicetos es esencial para la investigación, la conservación y la aplicación práctica de estos hongos en diversos campos.
Conclusiones y Perspectivas Futuras
Resumen de los Puntos Clave
Los Deuteromicetos, o hongos imperfectos, son un grupo diverso y complejo de hongos que desempeñan roles vitales en la ecología, la economía, la medicina y la cultura. Su clasificación ha sido un desafío, y su estudio continúa revelando nuevos conocimientos y aplicaciones.
Desafíos y Oportunidades de Investigación
La investigación en Deuteromicetos enfrenta varios desafíos y oportunidades:
- Identificación y Clasificación: La falta de una fase sexual observable plantea desafíos en la clasificación, pero también abre oportunidades para la investigación genética y molecular.
- Aplicaciones Médicas e Industriales: La exploración de nuevas aplicaciones en medicina, industria y agricultura es un campo prometedor.
- Conservación y ecología: La comprensión de su papel en los ecosistemas y la conservación de la biodiversidad es vital para la sostenibilidad.
Reflexiones Finales
Los Deuteromicetos son una maravilla de la naturaleza, llenos de misterio y potencial. Su estudio no solo enriquece nuestra comprensión de la biología y la ecología sino que también tiene un impacto tangible en nuestras vidas diarias. Desde la producción de antibióticos hasta la mejora de la calidad del suelo, su importancia no puede ser subestimada.
La exploración continua de los Deuteromicetos promete descubrimientos emocionantes y avances significativos en diversos campos. La colaboración entre científicos, educadores, artistas y conservacionistas puede llevar a una apreciación más profunda y a la utilización responsable de estos hongos únicos.
La era de los Deuteromicetos está lejos de haber terminado; en cambio, estamos en un umbral emocionante de descubrimiento y aplicación. La curiosidad, la innovación y el respeto por estos organismos pueden llevarnos a un futuro donde los Deuteromicetos continúan sorprendiéndonos y beneficiándonos de maneras inimaginables.
Referencias:
- Hawksworth, D. L. (1979). The fungal dimension of biodiversity: magnitude, significance, and conservation. Mycological Research, 95(6), 641-655.
- Pitt, J. I., & Hocking, A. D. (2009). Fungi and Food Spoilage (3rd ed.). Springer.
- Samson, R. A., & Varga, J. (2009). Aspergillus in the Genomic Era. Wageningen Academic Publishers.
- Bennett, J. W. (2010). An Overview of the Genus Aspergillus. In Aspergillus: Molecular Biology and Genomics (pp. 1-17). Caister Academic Press.
- Alexopoulos, C. J., Mims, C. W., & Blackwell, M. (1996). Introductory Mycology (4th ed.). John Wiley & Sons.



